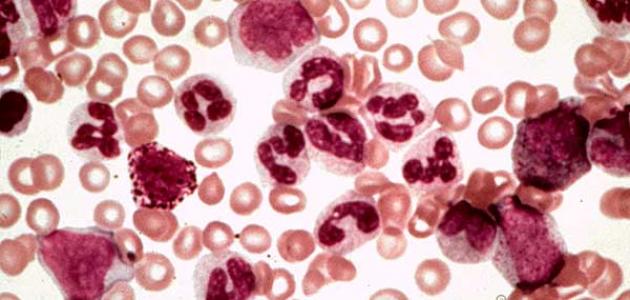

أسباب السرطان.. 5 عوامل تؤدي إلى أورام المعدة والثدي والرحم والمخ والدم
أسباب السرطان كثيرة ومتعددة، منها ما يمكن تجنبه بتحقيق سبل الوقاية من مرض السرطان، ومنها ما لا يمكن تجنبه مثل التقدم بالعمر، والعوامل الوراثية، ولذلك سنوضح لكم عبر القاهرة 24، أهم أسباب السرطان، مع تسليط الضوء على أسباب سرطان الثدي، وأسباب سرطان المعدة، وكذلك سرطانات الدم والمخ والرحم، فإلى التفاصيل.
أسباب السرطان
قبل توضيح أسباب السرطان لا بد من التنويه بأن مرض السرطان يحدث نتيجة الآتي:
- وجود طفرة جينية تحفز إحدى خلايا الجسم على النمو بشكل سريع يؤدي إلى ظهور خلايا خبيثة تحل محل الخلايا الطبيعية.
- وبعد حدوث الطفرة الجينية سيفشل الجسم في السيطرة على نمو وانتشار الخلايا الخبيثة ما يجعلها مستمرة في الانقسام والتراكم.
- حدوث طفرات في جينات المادة الوراثية بالجسم وهي أكثر أنواع الطفرات المسجلة في حالات الإصابة بالسرطان.

ومن محفزات الإصابة بـ أسباب السرطان ما يلي:
التقدم بالعمر
تظهر أغلب أنواع السرطان في عمر مبكر جدا بعد تخطي الـ 65 عاما، وذلك لأن المرض يحتاج إلى أعوام عديدة حتى يتحور وتبدأ أعراضه في الظهور، ولكن ذلك لا ينفي إصابة بعض الأطفال بـ مرض السرطان، خصوصًا سرطان الدم.
طبيعة الحياة
نمط الحياة له عامل كبير ضمن أسباب السرطان، مثل التدخين وإدمان الكحول، والتعرض المفرط لأشعة الشمس الضارة، والسمنة المفرطة، وإقامة علاقات جنسية غير آمنة أو مشروعة، كلها عوامل خطر يمكن تجنبها نهائيا لتحقيق الوقاية من مرض السرطان؟
العوامل الوراثية
تزداد فرص إصابة الشخص داخل العائلة الواحدة الذي عانى أفرادها من مرض السرطان، حيث يسهل انتقال الطفرات الجينية بين الأقارب من الدرجة الأولى، ما يعني ضرورة إجراء فحوصات دورية لمنع ظهور أسباب السرطان المحتملة حتى وإن كانت بنسب ضئيلة.
الحالة الصحية
الحالة الصحية للفرد توضع ضمن أسباب السرطان، حيث تكرار الإصابة بالعدوى الفيروسية أو الإصابة بالتهاب القولون التقرحي، أو جرثومة المعدة، وكذلك فيروس الورم الحليمي البشري، والتهاب الكبد الوبائي بي وفيروس سي، كلها عوامل صحية تحفز على الإصابة بـ أنواع السرطان المختلفة.
سموم البيئة
كثرة التعرض للتلوث البيئي والسموم التي تنطلق من المصانع، وعوادم السيارات، ومواد البناء، واحتراق المواد البلاستيكية، والتدخين السلبي، والمبيدات الحشرية وغيرها من سموم البيئة كلها عوامل ضارة للإصابة بـ مرض السرطان.
أسباب سرطان الثدي
تنشأ أسباب سرطان الثدي عندما تتعطل الوظائف الطبيعية المتحكمة في نمو خلايا الثدي وانقسامها، ما يؤدي إلى ظهور الورم الخبيث والذي يسهل علاجه إذا ما تم تشخيصه في مرحلة مبكرة.
ويمكن رصد أسباب سرطان الثدي الطبية في الآتي:
- الجنس، حيث تصاب النساء بمعدلات أعلى بكثير عن الرجال بـ سرطان الثدي.
- العمر، حيث تزداد أسباب سرطان الثدي في الظهور مع التقدم بالعمر بعد سن الخمسين.
- الجينات الوراثية، حيث تزداد فرص انتقال سرطان الثدي والمبيض لدى نساء العائلة الواحدة.
- بدء الطمث المبكر يزيد احتمالية الإصابة بسرطان الجهاز التناسلي الأنثوي بالإضافة إلى سرطان الثدي.
- الثدي ذو الأنسجة عالية الكثافة لديه احتمالات أعلى للإصابة بالسرطان.
- التعرض للعلاج الإشعاعي بالقرب من منطقة الثدي قبل عمر الثلاثين.
- إنجاب الأطفال في عمر مبكر بعد سن الثلاثين.
- عدم إرضاع الطفل الرضاعة الطبيعية.
- السمنة المفرطة مع انقطاع الطمث مبكرًا.
- تناول حبوب منع الحمل يرتبط بـ أسباب سرطان الثدي.
- العلاج بالهرمونات البديلة بعد انقطاع الطمث يحفز الإصابة بسرطان الثدي.

أسباب السرطان في الرحم
أسباب السرطان في الرحم يعد من أعلى احتمالات الشفاء التام مع العلم بأن أغلب حالات الإصابة بـ السرطان في الرحم ينتج عن الإصابة بفيروس الورم الحليمي البشري، والنساء بين 35 و44 عامًا هن الأكثر عرضة للإصابة به.
ونرصد لكم أسباب السرطان في الرحم كالتالي:
- تناول الأدوية الهرمونية لفترة طويلة تزيد على 5 سنوات.
- بدء ممارسة العلاقة الحميمة في سن مبكرة.
- تدخين السجائر تزيد من فرص الإصابة بـ سرطان عنق الرحم.
- الإصابة ببعض أمراض نقص المناعة.
- الإصابة بأحد الأمراض المنقولة جنسيا.
- السمنة المفرطة التي تسبب خللا في الهرمونات.
- عدم المرور بالحمل طوال سنوات الإنجاب المفترضة.
- بدء الدورة الشهرية قبل عمر 12 عاما.
- تأخر الوصول لسن اليأس بانقطاع الطمث.
- ارتفاع هرمون الأستروجين دون البروجسترون.
- الإصابة بـ سرطان الثدي تحفز الإصابة بـ سرطان الرحم.

أسباب سرطان المعدة
سرطان المعدة واحد من أخطر أنواع السرطانات التي تصيب نسبة من الأشخاص مع وجود عوامل خطر تزيد من فرص تحول الخلايا المبطنة للمعدة إلى خلايا سرطانية خبيثة.
ويمكن توضيح أسباب سرطان المعدة كالتالي:
- تناول الأطعمة الغنية بملح الطعام، والأطعمة المدخنة، والأطعمة المقلية بشكل مفرط.
- تناول اللحوم المصنعة واللحوم الحمراء والحبوب المكررة والأطعمة المحفوظة بالتبريد.
- التدخين واحد من أهم أسباب سرطان المعدة، خصوصا لدى الرجال بنسبة 60%.
- السمنة وارتفاع مؤشر كتلة الجسم لأكبر من 30 يزيد خطر الإصابة بـ سرطان المعدة والمريء.
- التعرض لمواد كيميائية بشكل متكرر يرفع خطر الإصابة بسرطان المعدة بالمقارنة مع الأشخاص غير المعرضين لهذه المواد.
- الخضوع لجراحات سابقة في المعدة، أو الإصابة بـ جرثومة المعدة، أو ارتجاع المريء كلها عوامل مرضية محفزة على السرطان.
- العوامل الوراثية للإصابة بـ أسباب سرطان المعدة تزيد من إصابة الأقارب من الدرجة الأولى بنفس المرض.
- يصيب سرطان المعدة الرجال بمعدل الضعف عن إصابة النساء، خصوصا لمن تقدم بالعمر فوق سن الـ 50 عاما.
أسباب سرطان الدم
تحدث أسباب سرطان الدم أو كما يطلق عليه طبيا اللوكيميا أو ابيضاض الدم عندما يتلف الحمض النووي لخلايا الدم غير الناضجة، وخصوصا خلايا الدم البيضاء التي ستستمر في النمو والتراكم ما يجعلها تحتل مساحة كبيرة من الدم والنخاع العظمي.
وعلى الرغم من عدم معرفة السبب الرئيسي وراء الإصابة بـ أسباب سرطان الدم مثل باقي أنواع السرطانات الأخرى، فإن هناك بعض العوامل المحفزة كالتالي:
- التعرض للعلاج الكيماوي أو الإشعاعي في سنوات سابقة يزيد من فرص الإصابة بـ سرطان الدم.
- الاضطرابات الوراثية، حيث تزداد فرص إصابة الأشخاص من متلازمة داون باللوكيميا.
- التعرض المفرط لسموم البيئة، ومنها البنزين وكذلك التدخين يساهم في زيادة خطر الإصابة ببعض أنواع سرطان الدم، وخاصة سرطان الدم النقوي الحاد.
- وجود تاريخ عائلي للإصابة بسرطان الدم، حيث تزداد فرص إصابة أفراد العائلة الواحدة بنفس المرض.
أسباب سرطان المخ
تحدث أسباب سرطان المخ Brain cancer عندما تتغير المعلومات الموجودة في الحمض النووي الصبغي لخلايا المخ، وهو إما يحدث لتغيرات جينية موروثة، وإما لتغيرات جينية مكتسبة بفعل عوامل محفزة.
ومن أسباب سرطان المخ الطبية ما يلي:
- العوامل الوراثية.
- التعرض للتلوث البيئي.
- التعرض لبعض أنواع الإشعاعات في الرأس.
- تدخين السجائر.
- الإصابة بفيروس الإيدز.
- التقدم في العمر.
أسباب السرطان عند الأطفال
تنشأ أسباب سرطان الدم عند الأطفال إما بسبب سرطان الدم، أو سرطان الدماغ، مع وجود عوامل وراثية متسببة في المرض بنسبة 10%، وقد أوضحت الجمعية الأمريكية للسرطان أهم أسباب السرطان عند الأطفال في الآتي:
- مشكلات صحية تعرض لها الطفل وهو جنين في رحم الأم مثل تعرضه لعدوى أو إشعاع.
- الأطفال المصابون بـ متلازمة داون أو تشوهات في الكروموسومات أكثر عرضة للسرطان بنسبة 20%.
- التغيرات الجينية التي تحدث في خلية واحدة داخل جسم الطفل تزيد من احتمالات إصابته بالسرطان.
- تعرض الطفل لكتلة أو ورم متروك دون علاج من الممكن أن يتوسع فيما بعد ويسبب له السرطان.
- العوامل البيئية الضارة ونمط الحياة الخاطئ يصيب الطفل بالسرطان.
- إصابة الأطفال بالعدوى المزمنة من عوامل الخطر للإصابة بـ أسباب السرطان عند الأطفال.
- عدم الاهتمام بتطعيم الطفل أو فحصه طبيا أثناء مرضه بأي عدوى عوامل سلبية تصيبه بالسرطان في وقت لاحق.
- العوامل الوراثية من أسباب السرطان عند الأطفال بنسبة 10%.
- التقدم في السن لدى الوالدين أثناء إنجاب طفلهم.


